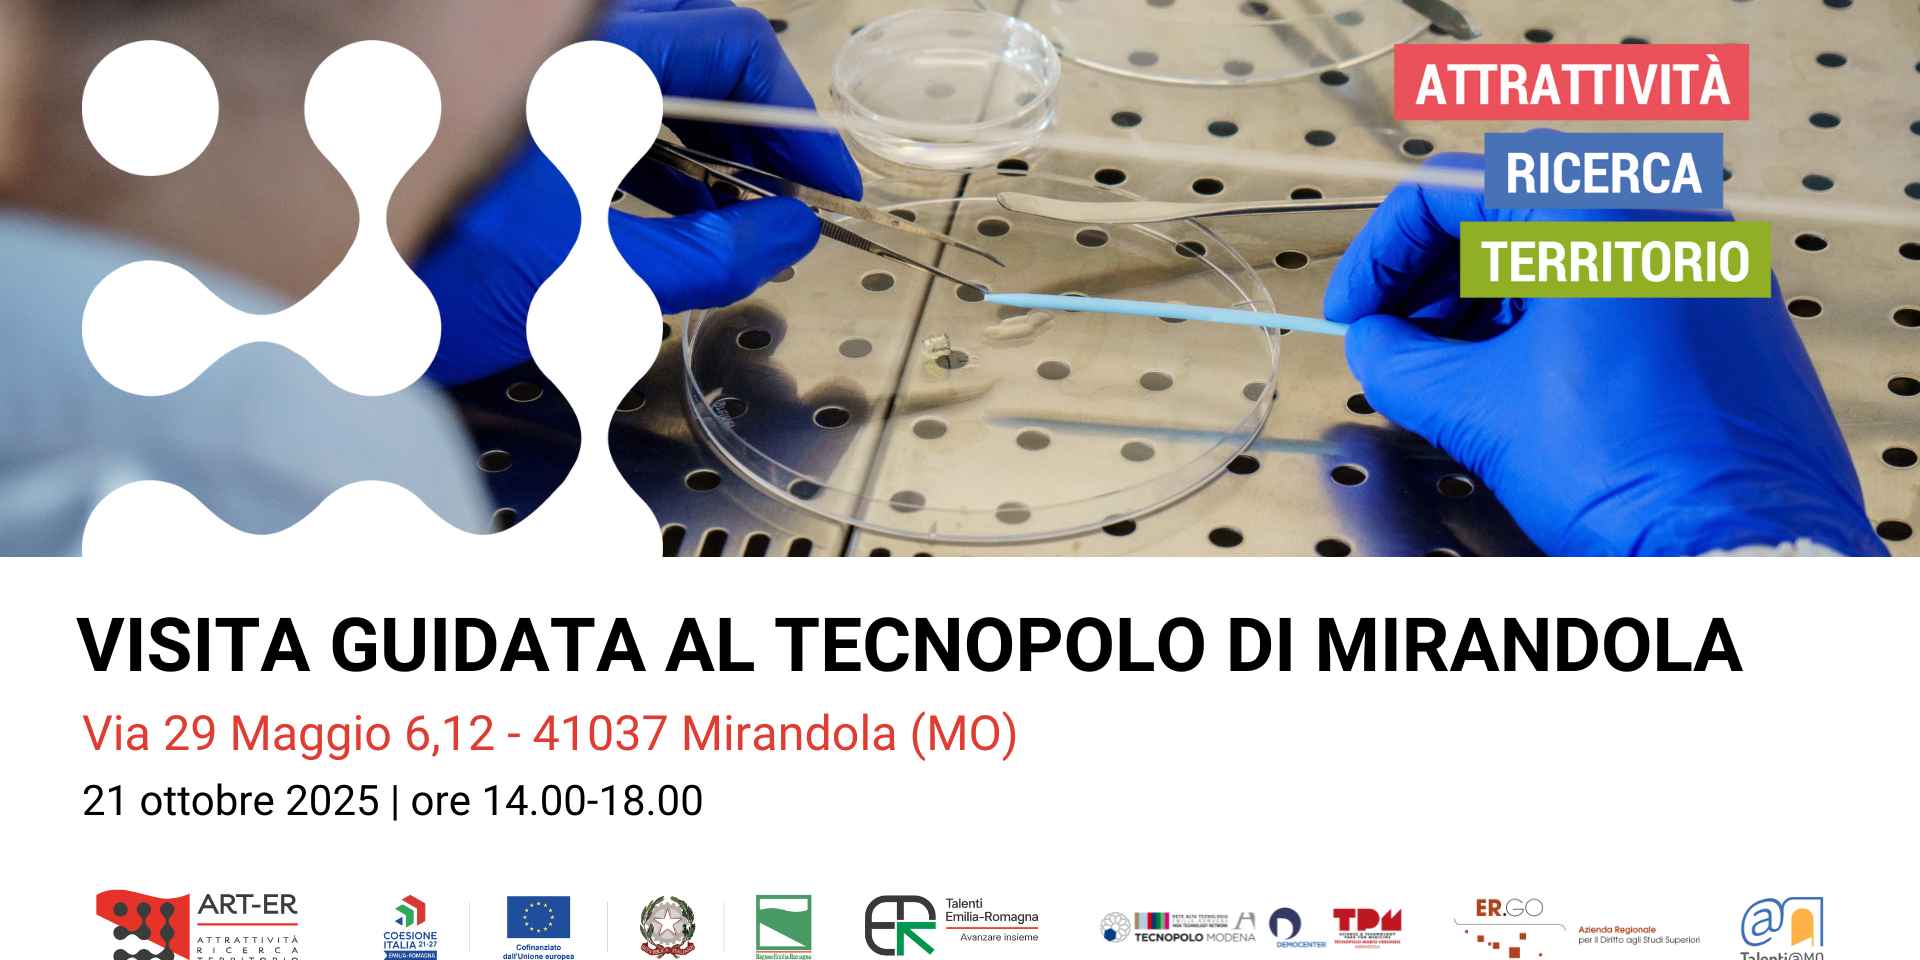

Ti interessa scoprire le ultime ricerche e innovazione nell’ambito del biomedicale?
Ti invitiamo a partecipare a una visita guidata al Tecnopolo di Mirandola (TPM) “Mario Veronesi”, organizzata da ART-ER ed ER.GO in collaborazione con Fondazione Democenter e Talenti@MO.
Il Tecnopolo, situato nel cuore del distretto biomedicale mirandolese, è un laboratorio di ricerca accreditato dalla Rete Alta Tecnologia Emilia-Romagna.
Il 21 ottobre 2025, dalle 14:00 alle 18:00, avrai l’opportunità di:
- Scoprire da vicino i LABS del Tecnopolo
- Assistere a dimostrazioni pratiche guidate da esperti
- Comprendere le applicazioni e l’impatto delle soluzioni innovative in fase di sviluppo.
Questo evento gratuito è rivolto a talenti, diplomati, studenti universitari e ITS, laureati, dottorandi e ricercatori.
È l’occasione perfetta per connettersi con l’ecosistema regionale della ricerca e dell’innovazione e vedere come la ricerca si traduce in applicazioni concrete.
I posti sono limitati a 15 partecipanti per motivi di sicurezza e fruibilità della visita. Per garantirti l’ingresso, è necessario iscriversi entro e non oltre il 14 ottobre 2025 compilando questo form online.
Agenda della giornata:
- 14:00 Punto di ritrovo presso la stazione di Modena.
- 14:15 Partenza in pullman per Mirandola.
- 15:00 Presentazione dell’Ecosistema Regionale dell’Innovazione a cura di ART-ER ed ER.GO.
- 15:20 Tour dei LABS con dimostrazioni pratiche a cura di Simona Sbardelatti, Responsabile Progetti Finanziati del TPM.
- 17:20 Chiusura lavori e rientro a Modena.
Non perdere questa opportunità unica di approfondire le tue conoscenze e di connetterti con il futuro della ricerca biomedicale.
Iscriviti ora e assicurati il tuo posto!
Hai bisogno di contattarci? Scrivi a talenti_mo@art-er.it